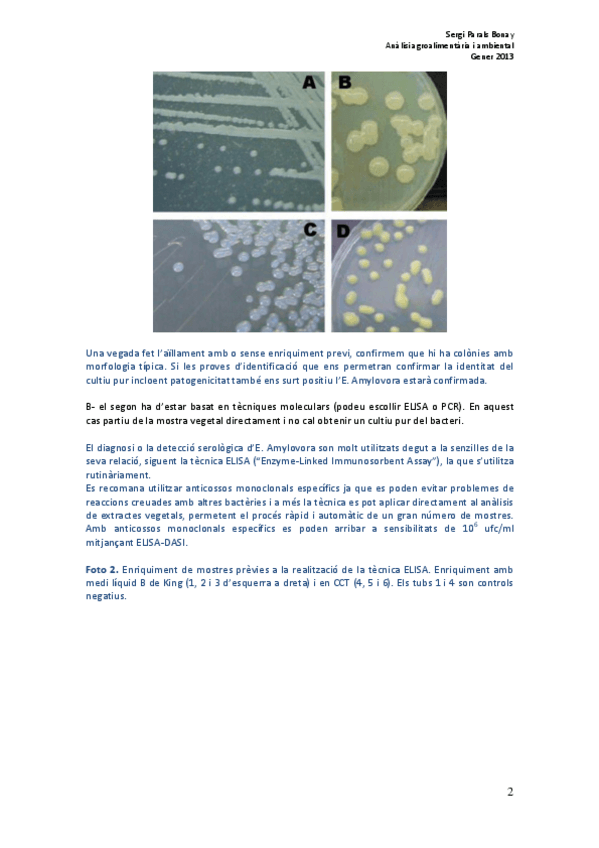

Análisis Agroalimentario y Ambiental
Todo
Ejercicios
Exámenes
Prácticas
chevron_left
chevron_right
Protocols per a la identificació del bacteri Erwinia amylovora (bacteri causant del foc bacterià).
examenes
-
Examens 2010, 2011 I 2012
Part d'anàlisi quimic
ejercicios
-
Exercici Butlletí D'analisi
He publicado nuevos ejercicios de 2º Análisis Agroalimentario y Ambiental: Exercici Butlletí D'analisi
He publicado nuevos practicas de 2º Análisis Agroalimentario y Ambiental: practica 1 2 i 3.pdf

¡Estás al día!
Has visto todos los archivos